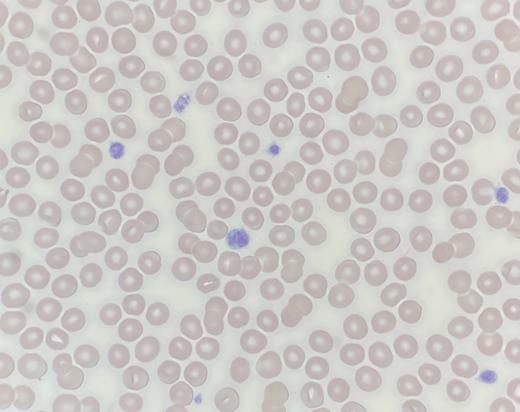
Peripheral blood smear.

A 19-year-old woman presented to clinic for evaluation of thrombocytopenia incidentally noted on her annual physical. She had normal menstrual periods and denies any personal or family history of bleeding or bruising. While she had no other significant medical history, her family history revealed that her father needed hearing aids at a young age. Laboratory studies showed a white blood cell count of 7.3 × 109/L with a normal differential, hemoglobin of 12.9 g/dL, and platelet count of 81 × 109/L. Platelet aggregometry showed normal aggregation to arachidonic acid, adenosine diphosphate (ADP), collagen, epinephrine, and ristocetin. Her peripheral smear is shown in the Figure.
What is the diagnosis?
Acute immune thrombocytopenia purpura
Bernard-Soulier syndrome
MYH9-related disorder
Chediak-Higashi syndrome
Gray platelet syndrome
For the solution to the quiz, visit The Hematologist online, https://ashpublications.org/thehematologist/pages/quality-over-quantity.
Competing Interests
Dr. Chien, Dr. Lo, and Dr. Glader indicated no relevant conflicts of interest.